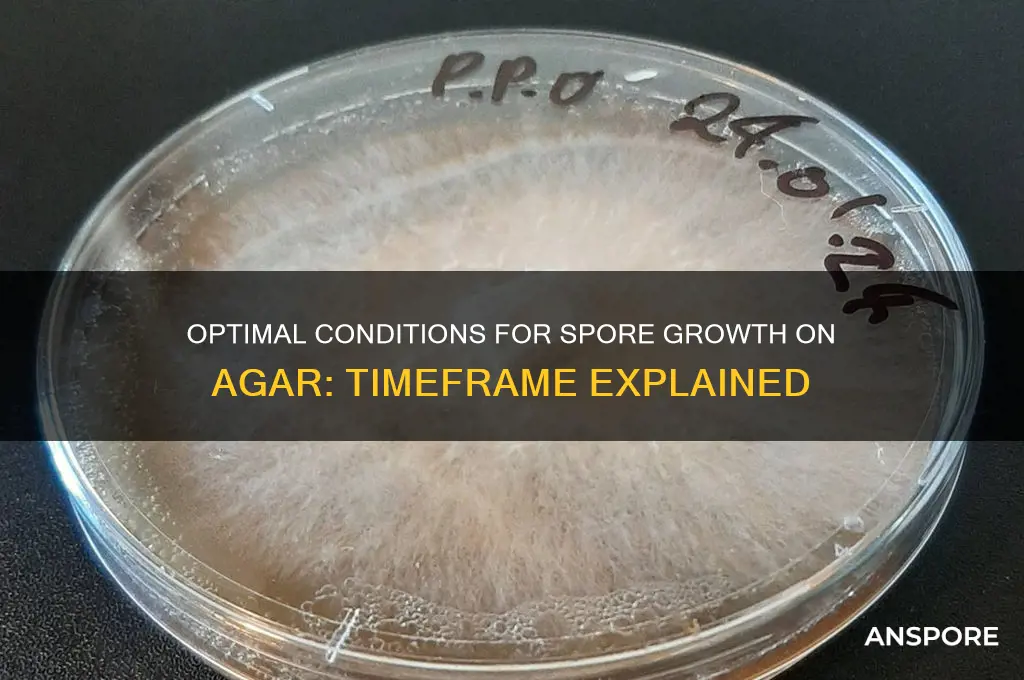
how long for spore to grow on agar

Growing spores on agar is a fundamental technique in microbiology, allowing researchers to cultivate and study various microorganisms. The time it takes for spores to grow on agar can vary significantly depending on the species of the organism, the type of agar used, and environmental conditions such as temperature and humidity. Generally, spore germination and visible colony formation can occur within 24 to 48 hours for fast-growing bacteria, while slower-growing fungi or certain bacterial species may take several days to a week. Optimal conditions, such as maintaining the correct incubation temperature and ensuring sterile techniques, are crucial for successful and timely growth. Understanding these factors is essential for accurate experimentation and identification in microbiological studies.
| Characteristics | Values |
|---|---|
| Optimal Temperature Range | 25°C to 30°C (77°F to 86°F) |
| Typical Growth Time | 3 to 7 days |
| Minimum Growth Time | 24 to 48 hours (for fast-growing species) |
| Maximum Growth Time | Up to 14 days (for slow-growing or dormant spores) |
| Agar Type Influence | Nutrient-rich agar (e.g., Potato Dextrose Agar) speeds up growth |
| Humidity Requirement | High humidity (near 100%) is essential for spore germination |
| Light Exposure | Some spores require light for germination; others are light-sensitive |
| pH Range | Optimal pH: 5.5 to 7.5 |
| Oxygen Requirement | Most spores require aerobic conditions |
| Inhibiting Factors | High salt concentration, extreme temperatures, or antimicrobial agents |
| Species Variability | Growth time varies significantly between fungal and bacterial spores |
| Sterility of Environment | Sterile conditions are crucial to prevent contamination |
| Hydration Requirement | Spores must absorb water to initiate germination |
| Storage Impact | Properly stored spores can remain viable for years, affecting growth time |
Explore related products
What You'll Learn

Optimal temperature range for spore germination on agar plates
Spore germination on agar plates is a temperature-sensitive process, with optimal ranges varying by species. For *Bacillus subtilis*, a mesophile commonly studied in labs, the ideal temperature falls between 25°C and 37°C. At 30°C, germination typically occurs within 2–4 hours, while at 25°C, it may extend to 6–8 hours. Temperatures above 45°C or below 15°C significantly inhibit germination, as enzymes critical for the process denature or become inactive. Understanding these thresholds ensures consistent and efficient growth in experimental settings.
For thermophilic spores, such as those from *Geobacillus stearothermophilus*, the optimal temperature range shifts dramatically. These spores thrive at 50°C to 70°C, with germination occurring within 1–3 hours at 60°C. Attempting to germinate thermophilic spores at mesophilic temperatures (e.g., 37°C) can delay or prevent growth entirely. Researchers must tailor incubation conditions to the species’ thermal preferences, using precision incubators to maintain stability within ±1°C.
In contrast, psychrophilic spores, like those from *Psychrobacter* species, germinate best at colder temperatures, typically between 4°C and 15°C. At 10°C, germination may take 12–24 hours, reflecting adaptations to low-energy environments. While slower, this process is crucial for studying extremophiles and their applications in cold-environment biotechnology. Avoid abrupt temperature changes, as even brief exposure to higher temperatures can trigger stress responses, delaying or halting germination.
Practical tips for optimizing spore germination include preheating the agar plates to the target temperature before inoculation to minimize thermal shock. For mixed-species samples, consider sequential incubation at different temperatures to isolate specific spore types. Always verify species-specific requirements, as even closely related organisms may exhibit distinct thermal optima. Accurate temperature control is not just a technical detail—it’s the linchpin of successful spore germination on agar.
Is Milky Spore Powder Safe? Potential Risks to Humans Explained
You may want to see also

Effect of humidity levels on spore growth duration
Spores, the resilient survival structures of fungi, require specific environmental conditions to germinate and grow on agar. Among these, humidity plays a pivotal role, acting as a catalyst or inhibitor depending on its level. Understanding this relationship is crucial for both laboratory cultivation and real-world applications, such as food preservation or mold control.
High humidity, typically above 70%, accelerates spore germination and growth on agar. This is because water vapor in the air facilitates the absorption of moisture by the spore, rehydrating it and triggering metabolic processes. For instance, *Aspergillus niger* spores, commonly found in indoor environments, can germinate within 24 hours at 80% relative humidity (RH) on potato dextrose agar (PDA). In contrast, at 50% RH, germination may take up to 48–72 hours, assuming optimal temperature (25–30°C) and nutrient availability.
However, excessively high humidity (above 90%) can hinder growth by promoting waterlogging on the agar surface, which restricts oxygen exchange and may lead to fungal death. This is particularly relevant for species like *Penicillium*, which thrive in moderately humid conditions (70–85% RH). To optimize growth, researchers often use humidity-controlled chambers, maintaining RH at 75–80% for most fungal species.
Low humidity, below 60%, significantly delays spore germination and may prevent growth altogether. Spores in such environments remain dormant, as insufficient moisture inhibits the activation of enzymes necessary for cell wall rupture and hyphal extension. For example, *Cladosporium* spores, common outdoor allergens, require at least 65% RH to initiate growth on agar. Practical applications of this knowledge include dehumidification strategies in buildings to suppress mold growth, where maintaining indoor RH below 60% effectively inhibits spore germination.
To manipulate humidity levels for spore cultivation, researchers employ desiccators with saturated salt solutions to achieve precise RH values. For instance, a potassium acetate solution provides 23% RH, while potassium nitrate yields 58% RH. Conversely, placing a water reservoir inside a sealed container with the agar plate can elevate RH to 90–95%. These techniques allow for controlled experiments to study the humidity-growth relationship.
In conclusion, humidity levels directly influence spore growth duration on agar, with optimal germination occurring at 70–85% RH for most fungal species. While high humidity accelerates growth, it must be balanced to avoid waterlogging, and low humidity suppresses germination entirely. By controlling humidity, researchers and practitioners can predict and manipulate spore behavior, whether for scientific study, food safety, or environmental management.
From Barracks to Beliefs: Can Military Cities Transform into Religious Hubs?
You may want to see also

Impact of agar nutrient composition on spore development time
The time it takes for spores to germinate and develop on agar is not a fixed constant but a variable influenced significantly by the nutrient composition of the agar itself. This relationship is particularly critical in microbiology, where precise control over growth conditions is essential for research, cultivation, and identification of microorganisms. For instance, a study comparing the growth rates of *Bacillus subtilis* spores on nutrient-rich agar (containing 2% peptone, 1% yeast extract, and 1% glucose) versus minimal agar (with only 0.1% glucose) found that spores on the nutrient-rich agar germinated within 4–6 hours, while those on minimal agar took 12–18 hours. This stark difference underscores the direct impact of nutrient availability on spore development time.
To optimize spore germination and growth, it’s instructive to consider the specific nutrient requirements of the target organism. For example, fungi like *Aspergillus niger* thrive on agar supplemented with 1% malt extract and 0.5% peptone, with visible colony growth observed within 24–48 hours. In contrast, obligate anaerobes such as *Clostridium* species require agar enriched with 5% sheep blood and reduced oxygen levels, which can extend germination time to 72 hours due to the slower metabolic processes under anaerobic conditions. These examples highlight the need to tailor agar composition to the organism’s metabolic needs, ensuring that essential nutrients are available in sufficient quantities to support rapid and efficient spore development.
A comparative analysis of agar formulations reveals that the concentration of carbon sources, nitrogen sources, and growth factors plays a pivotal role in determining spore development time. For instance, increasing the glucose concentration from 0.5% to 2% in agar can reduce the germination time of *Aspergillus* spores by up to 50%, as glucose serves as a readily metabolizable energy source. Similarly, the addition of vitamins (e.g., 0.1% B vitamins) can accelerate the growth of fastidious organisms like *Lactobacillus*, which otherwise exhibit prolonged lag phases. However, excessive nutrient concentrations can be counterproductive, as they may lead to osmotic stress or nutrient toxicity, inhibiting spore germination altogether.
Practical tips for optimizing agar nutrient composition include starting with a standard nutrient agar (e.g., 1.5% agar, 0.5% peptone, 0.3% beef extract, 0.5% sodium chloride) and adjusting components based on the organism’s requirements. For spore-forming bacteria, adding 1% starch or 0.1% ammonium sulfate can enhance germination by providing additional carbon and nitrogen sources. For fungi, incorporating 0.5% glycerol or 1% malt extract can promote faster mycelial growth. It’s also crucial to maintain pH levels between 6.8 and 7.2, as deviations can significantly impair spore viability and development. Regularly monitoring growth conditions, such as temperature (25–37°C for most microorganisms) and humidity, ensures that the agar environment remains conducive to spore germination and colony formation.
In conclusion, the impact of agar nutrient composition on spore development time is profound and multifaceted. By understanding the metabolic needs of specific microorganisms and adjusting agar formulations accordingly, researchers and cultivators can significantly reduce germination times and improve growth outcomes. This tailored approach not only enhances experimental efficiency but also ensures the reliability and reproducibility of results in microbiological studies. Whether working with bacteria, fungi, or other spore-forming organisms, the careful selection and optimization of agar nutrients remain a cornerstone of successful cultivation practices.
Peanut Butter and Mold Spores: Uncovering the Hidden Truth
You may want to see also
Explore related products

Role of pH in accelerating or delaying spore growth
Spores, the resilient survival structures of certain bacteria, fungi, and plants, exhibit varying growth rates on agar depending on environmental conditions. Among these, pH plays a pivotal role in either accelerating or delaying spore germination and subsequent colony formation. Understanding this relationship is crucial for optimizing laboratory cultures, food preservation, and even environmental control strategies.
PH acts as a gatekeeper, influencing the availability of nutrients, the activity of enzymes, and the overall metabolic processes within spores. Most spores have an optimal pH range for germination, typically between 6.0 and 8.0. Deviations from this range can significantly impact growth rates. For instance, a study on *Bacillus subtilis* spores revealed that germination was significantly delayed at pH 5.0 compared to pH 7.0, with a complete inhibition observed at pH 4.0. This highlights the sensitivity of spores to acidic conditions, which can disrupt cellular processes and hinder growth.
To illustrate the practical implications, consider the food industry. Controlling pH is a common preservation technique. Pickling, for example, relies on acidic conditions (typically pH 3.0-4.0) to prevent spore germination and growth of spoilage microorganisms. Conversely, in dairy fermentation, a slightly acidic pH (around 6.5) is maintained to encourage the growth of lactic acid bacteria while inhibiting the germination of unwanted spores.
This sensitivity to pH can be harnessed in laboratory settings to selectively cultivate specific spore-forming organisms. By adjusting the pH of the agar medium, researchers can create conditions favorable for the growth of target spores while suppressing the growth of contaminants. For instance, a pH of 8.5 might be used to selectively isolate alkaliphilic bacteria, which thrive in alkaline environments, while inhibiting the growth of most other spore-forming bacteria.
It's important to note that the relationship between pH and spore growth is not linear. While extreme pH values generally inhibit growth, the effect can be species-specific. Some spores possess mechanisms to tolerate a wider pH range, allowing them to survive in diverse environments. Therefore, understanding the specific pH requirements of the target organism is crucial for accurate experimentation and application.
Pilobolus Fungus: Unveiling the Unique Mechanism of Spore Dispersal
You may want to see also

Comparison of growth rates between different spore species on agar
The time it takes for spores to grow on agar varies significantly across species, influenced by factors like temperature, humidity, and nutrient availability. For instance, *Aspergillus niger*, a common mold, can begin visible colony formation within 24–48 hours under optimal conditions (25–30°C), while *Bacillus subtilis*, a bacterial spore, may take 12–24 hours at 37°C. In contrast, fungal spores like *Penicillium* often require 3–5 days to show substantial growth. These differences highlight the importance of species-specific incubation times when culturing spores on agar.
Analyzing growth rates reveals distinct patterns among spore types. Bacterial spores, such as those from *Clostridium botulinum*, typically germinate faster due to their simpler metabolic requirements, often visible within 8–12 hours under ideal conditions. Fungal spores, however, exhibit slower growth due to their complex cell walls and longer germination processes. For example, *Trichoderma* species may take 2–3 days to form visible colonies, even at optimal temperatures of 28–30°C. This comparison underscores the need for tailored incubation protocols based on the spore’s biological characteristics.
Practical tips for optimizing growth include maintaining consistent environmental conditions. For bacterial spores, use nutrient-rich agar (e.g., LB agar) and incubate at 37°C for rapid results. Fungal spores thrive on potato dextrose agar (PDA) at 25–30°C, with humidity levels above 80% to mimic natural environments. Additionally, sterilizing equipment and using aseptic techniques minimizes contamination, ensuring accurate growth rate comparisons. Regularly monitoring colonies at 12-hour intervals provides valuable data on species-specific development timelines.
A comparative study of *Aspergillus*, *Bacillus*, and *Penicillium* spores reveals intriguing insights. While *Bacillus* spores dominate in speed, *Aspergillus* spores excel in colony density, often covering the entire agar surface within 72 hours. *Penicillium*, though slower, produces distinctive blue-green colonies that are easily identifiable. These observations emphasize the trade-off between growth rate and morphological characteristics, which can aid in species identification and experimental planning.
In conclusion, understanding the growth rates of different spore species on agar is crucial for both research and practical applications. By tailoring incubation conditions and observing species-specific behaviors, scientists can optimize culturing processes and achieve reliable results. Whether working with bacterial or fungal spores, this knowledge ensures efficient and accurate experimentation, paving the way for advancements in microbiology and biotechnology.
Acetic Acid's Power: Can It Eliminate Bacterial Spores Effectively?
You may want to see also
Frequently asked questions
Spores usually begin to germinate within 12 to 24 hours on agar, depending on the species and environmental conditions.
Factors include temperature, humidity, nutrient availability, spore viability, and the specific species of the spore.
Yes, some spores, especially those from dormant or slow-growing species, may take up to several days or even weeks to show visible growth.
Optimal conditions such as maintaining the correct temperature (typically 25–30°C), using nutrient-rich agar, and ensuring proper humidity can accelerate spore growth.































